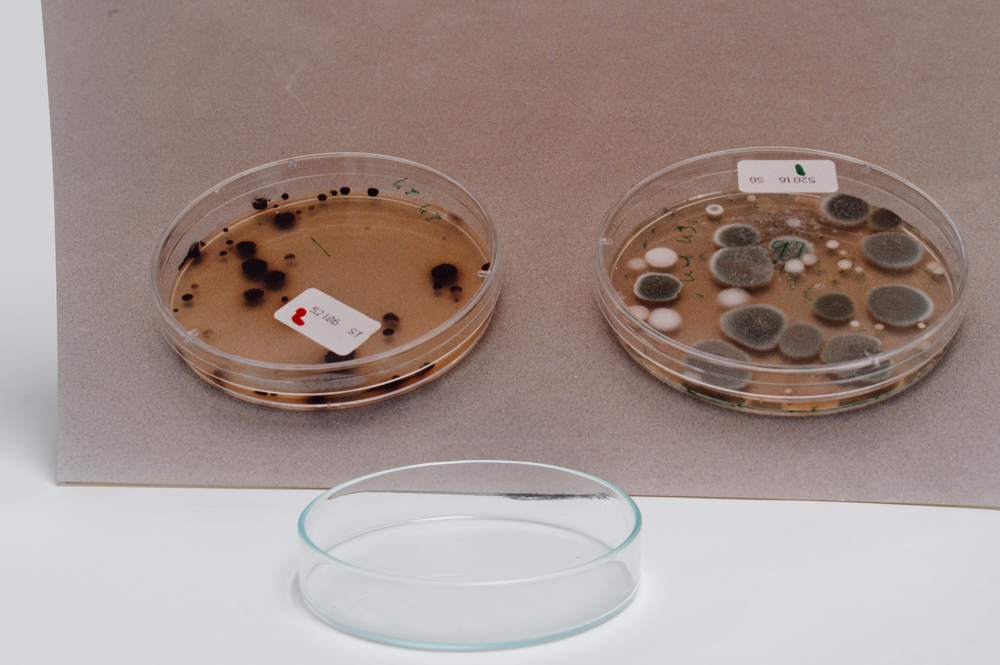

Veldstra, B.
Winkelman, Johan
Winkelman, Johan
2011-11-19
Dit verhaal maakt onderdeel uit van het project MijnDenHaag* Topstukken, waarbij Hagenaars gevraagd wordt naar hun eigen persoonlijke topstuk. 'Hygiëne. Vanaf 1980 gaf ik les aan de opleiding THW (Toegepaste Huishoudwetenschappen), die later overging in Facility Management (FM). Daar gaf ik les in hygiëne. Heel wat studenten heb ik bekend gemaakt met die onzichtbare microwereld. ...
V-HHM-0598
MijnDenHaag*
Haags Historisch Museum